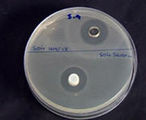

Honeybees and Mānuka trees
Although honey from New Zealand’s Mānuka trees looks a lot like other honeys, there is one important difference that makes it extra special.
Different honeys from different flowers
New Zealand’s honeybees get nectar from a number of different sources, including clover, dandelions, and some native trees. One source of nectar is the Mānuka tree (Leptospermum scoparium), which flowers during summer. Honey made from Mānuka nectar is thick, dark brown, high in sugar and has a distinctive flavour. It also has one other characteristic that makes it especially interesting…
What’s so special about Mānuka?
Mānuka honey is better than other honeys at healing wounds. Research at the University of Waikato has shown that this is because Mānuka honey has the highest antibacterial activity of all honeys.
This is because Mānuka honey contains a mysterious substance called the Unique Mānuka Factor. The activity of the Unique Mānuka Factor (UMF®) is responsible for Mānuka honey’s remarkable wound healing properties.
Despite a lot of effort, scientists have still not worked out what the mysterious substance is that makes Mānuka honey so special.
Making sure it’s Mānuka
Because Mānuka honey is so amazing, it can be sold for bigger profits.
In order to make Mānuka honey, beehives are placed in areas where there is lots of Mānuka. But you can’t follow every bee, so how can beekeepers know whether their honey is made from Mānuka nectar?
The taste and colour are a good first indication. A laboratory test for the UMF® activity is also key.
Testing for antibacterial power
Even once you have Mānuka honey, it turns out that some are better than others at killing bacteria and helping wounds to heal.
Scientists have devised a simple test to check how good the Mānuka honey is at killing bacteria. This means that different batches of Mānuka honey can then be rated.
The higher the UMF® number, the better the honey is at killing bacteria.
The first step of the test is to grow bacteria in a jelly-like layer called agar. Next, holes are cut in the agar and filled with honey solution. The honey diffuses into the agar. If it kills the bacteria, the agar goes clear and see-through. The amount of clearing represents the antibacterial strength of the honey.
Useful links
Honey bee heroes
Learn more about honey bees and how they pollinate flowers in the Pollination context on the Science Learning Hub.
www.sciencelearn.org.nz/Contexts/Pollination/Looking-Closer/Honey-bee-heroes
Metadata
- Published:
- 01 June 2007